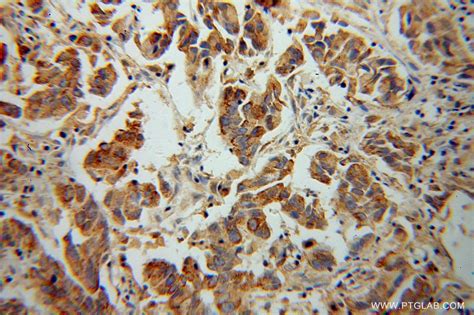
cypa antibody   ap proteintech

Jika kamu sedang mencari Cyp17a1, maka anda berada di halaman yang tepat. Kami menyediakan aneka Cyp17a1 yang bisa anda pesan online. Silakan hubungi kami via +6282245078486, jangan lupa sertakan juka gambar yang diinginkan.
Kami mengirim paket Cyp17a1 melalui berbagai ekspedisi, misalnya JNE, JNT, POS, dll. Kami juga menerima pembayaran via BCA/Mandiri/dll. Pengiriman biasanya tidak sampai seminggu sudah sampai dan kami sertakan pula nomor resi yang bisa digunakan untuk tracking barang secara online.

Tidak hanya Cyp17a1, anda juga bisa melihat gambar lain seperti
CYP1A2,
CYP2C9,
CYP2C19,
CYP2E1,
CYP3A4,
CYP2D6,
CYP3A5,
CYP2B6,
CYP2A6,
CYP1A1,
CYP1B1,
and CYP3A.
Berbagai Contoh Cyp17a1
Berikut kami sertakan berbagai contoh gambar untuk Cyp17a1, silakan save gambar di bawah dengan klik tombol pesan, anda akan kami arahkan pemesanan via WA ke +6282245078486.
 3935×2405
3935×2405
steroidal cypa inhibitors prostate cancer encyclopedia mdpi
Order Sekarang
 980×885
980×885
anti cytochrome p acypa rabbit monoclonal ab genuin
Order Sekarang
 850×687
850×687
cypacypa selectivity plot binding energies cypa
Order Sekarang
 394×242
394×242
p cypa variant disordered proton shuttle assembly retains
Order Sekarang
 850×698
850×698
modeled structure cypa depiction pathogenic variants
Order Sekarang
 650×488
650×488
biomatik corporation cytochrome p cypa polyclonal antibody
Order Sekarang
 800×800
800×800
rabbit polyclonal anti cypa antibody buy research highly
Order Sekarang
 320×320
320×320
expressions cypa levels testosterone concentrations
Order Sekarang
 2240×1260
2240×1260
cypa steroid hormone production testosterone estrogen dhea
Order Sekarang
 658×408
658×408
cypa deficient xy mice display susceptibility atherosclerosis
Order Sekarang
450×264
450×264
human cytochrome cypa structural basis compromised lyase
Order Sekarang
 400×300
400×300
anti homo sapiens human cypa antibody raised rabbit cusabio
Order Sekarang
 1632×2048
1632×2048
data cypa structure lead advances prostate cancer drug
Order Sekarang
 850×470
850×470
cypa hsdb akrc cypa expression dlk overexpressing
Order Sekarang
Temukan solusi terbaik untuk kenyamanan ruang Anda dengan Cyp17a1! Produk peredam suara dan panas ini menawarkan performa maksimal dengan harga yang terjangkau. Dapatkan kualitas unggul tanpa menguras kantong, dan nikmati suasana tenang serta sejuk di setiap sudut rumah atau kantor Anda. Pilih Cyp17a1 – pilihan cerdas untuk investasi jangka panjang!
Maaf, tidak ada yang cocok dengan kriteria yang Anda cari.
Apa yang ingin Anda lakukan?
« kembali ke Beranda atau gunakan kotak pencarian dibawah ini untuk mulai penelusuran baru.










